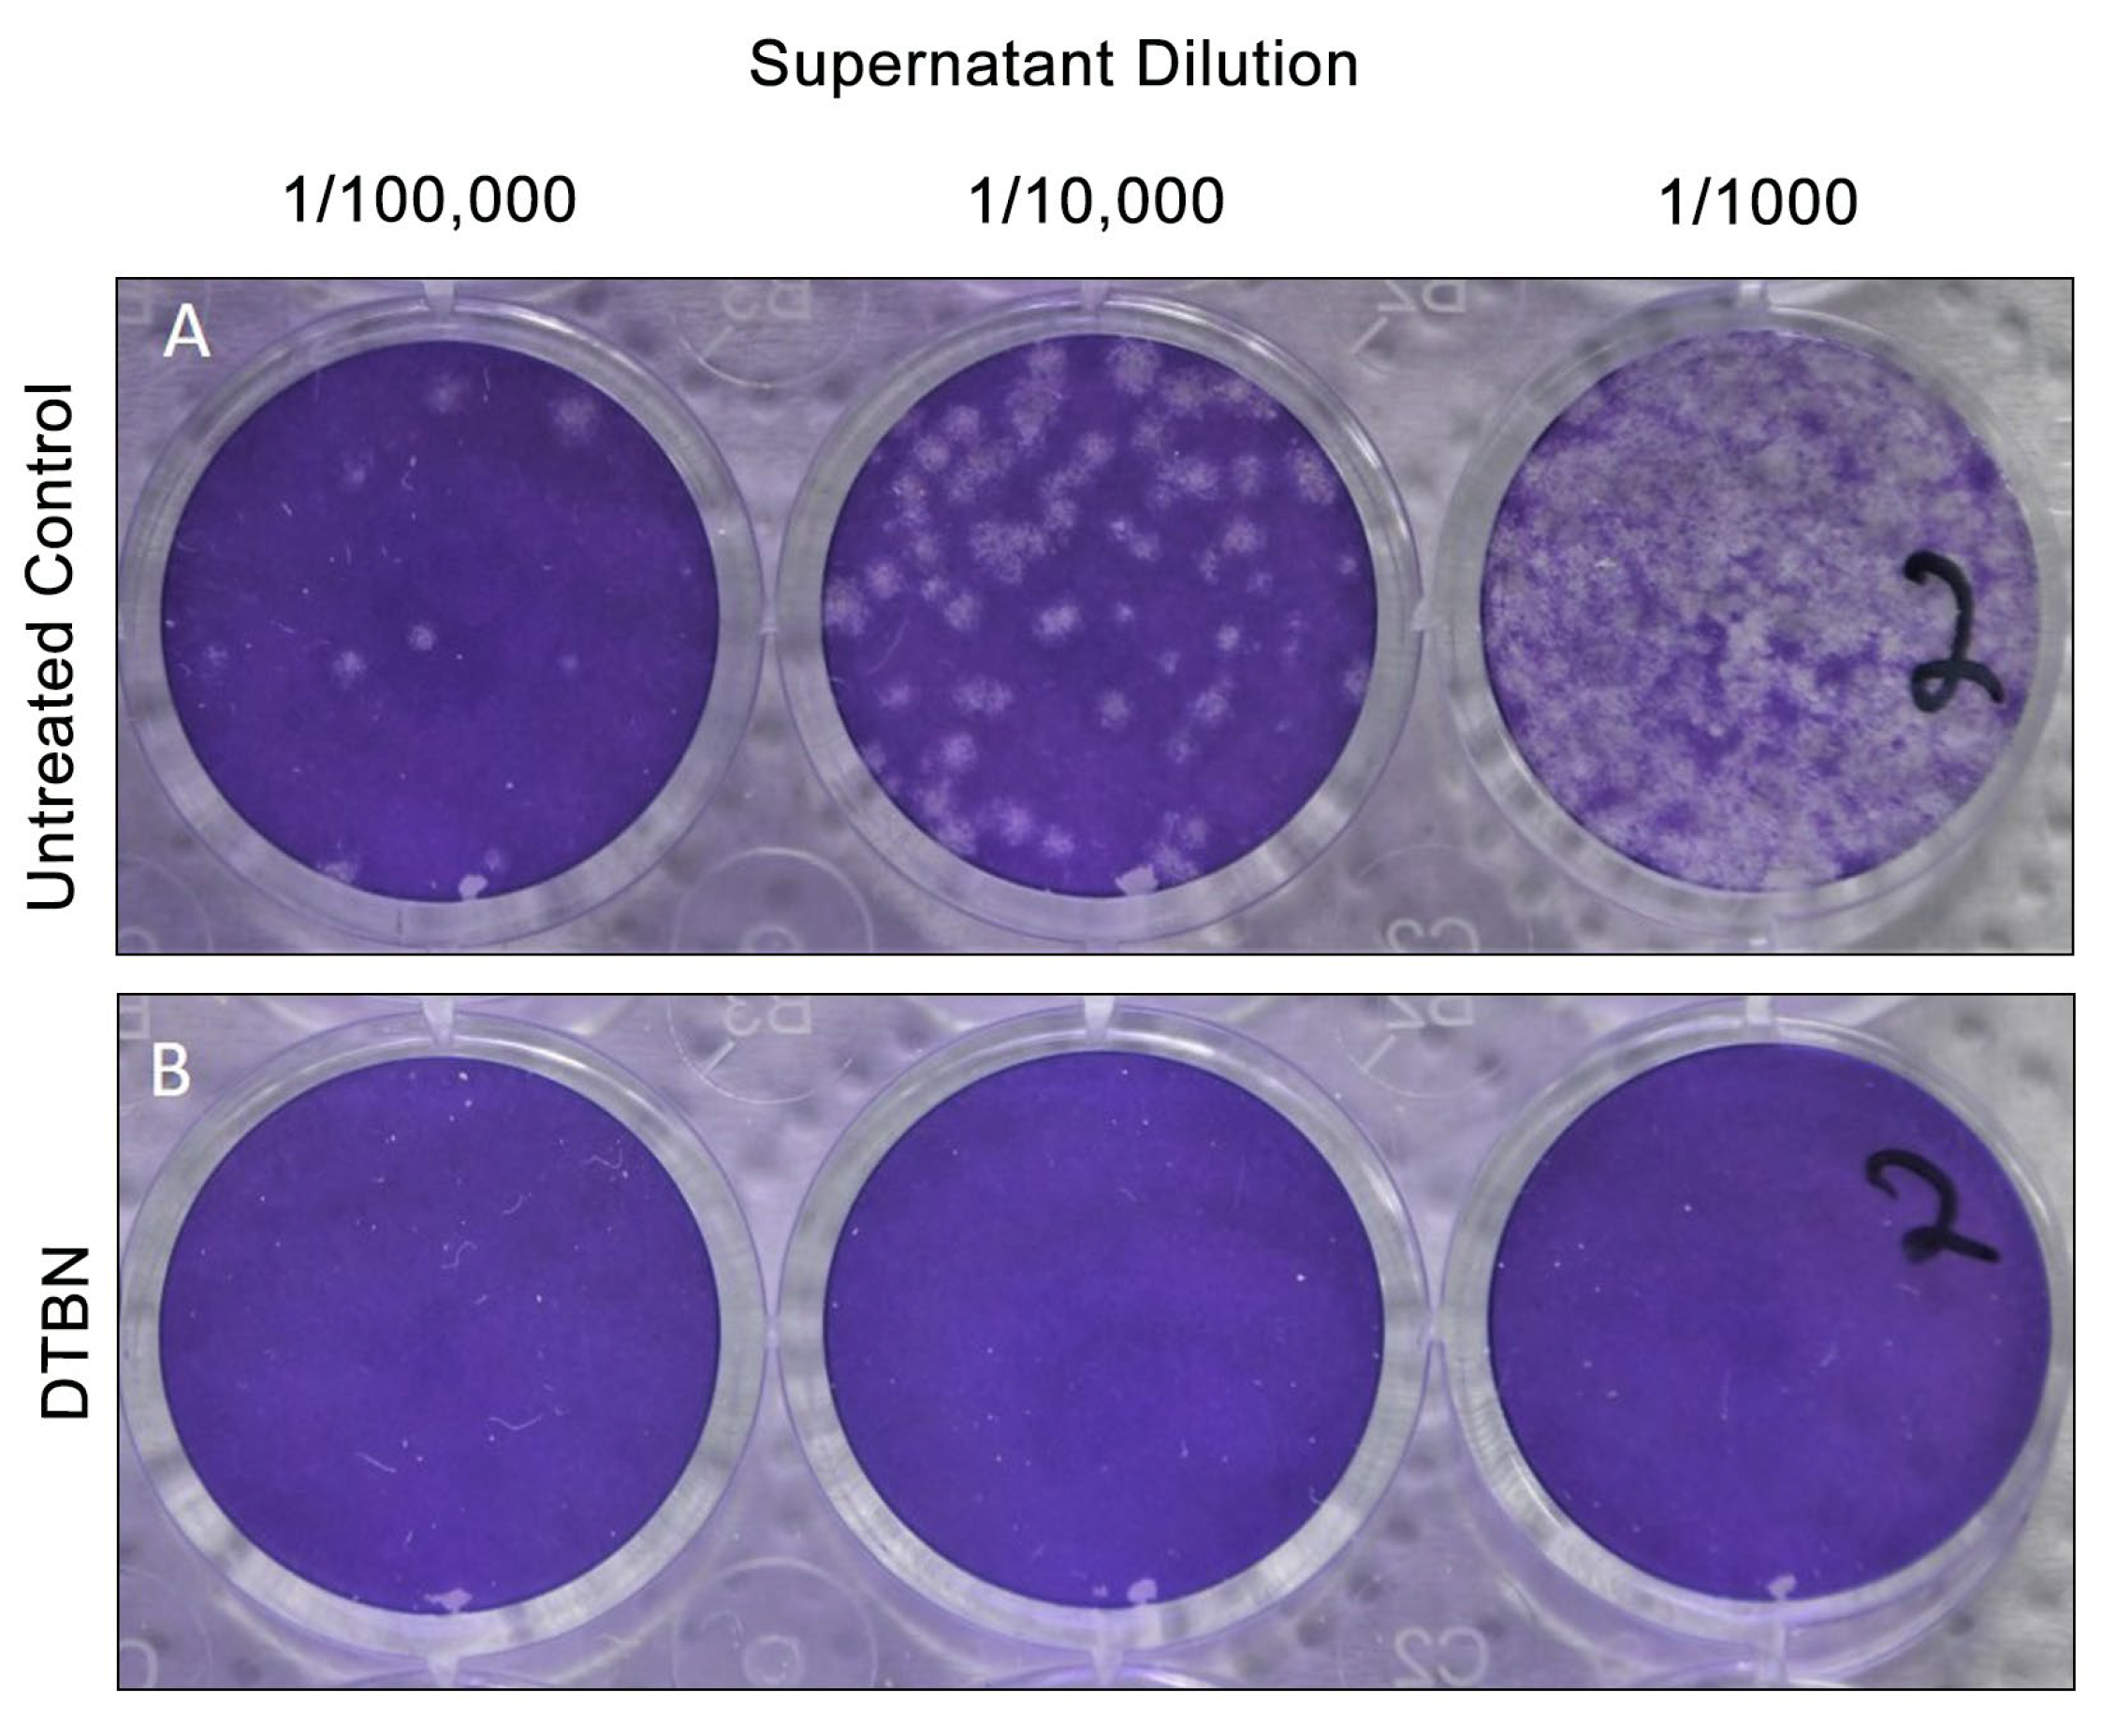
Ijms 24 08327 g003

In Vitro and In Vivo Therapeutic Potential of 6,6′-Dihydroxythiobinupharidine (DTBN) from Nuphar lutea on Cells and K18-hACE2 Mice Infected with SARS-CoV-2
Abstract
1. Introduction
2. Results
2.1. Determination of Half Maximal Inhibitory Concentration (IC50) of DTBN on Vero E6 Cells
2.2. DTBN Pretreatment of Vero E6 Cell Prior to Infection, Inhibits the Release of Infective Viral Particles to the Supernatant
2.3. DTBN Treatment of Vero E6 Cell following Infection, Inhibits the Release of Infective Viral Particles to the Supernatant
2.4. Survival of Infected Mice Treated with Vehicle or with DTBN
2.5. Expression of Viral Particles in Lungs of Vehicle and DTBN Treated Mice
2.6. In Silico Molecular Docking of DTBN and suramin to SARS-CoV-2 RNA Dependent RNA Polymerase (RdRp)
2.7. Molecular Dynamic (MD) Simulation
3. Discussion
4. Materials and Methods
4.1. Cells
4.2. Virus
4.3. Cell Viability
4.4. Animal Experiments
4.5. Immunochemistry and Evaluation of Viral Presence in the Lung Sections
4.6. Computational Methodology
4.6.1. The Molecular Docking and MM-GBSA Refinement
ΔGBind Self cont + ΔGBind Solv GB + ΔGBind vdw)
4.6.2. Molecular Dynamics (MD) Simulation
Supplementary Materials
Author Contributions
Funding
Institutional Review Board Statement
Informed Consent Statement
Data Availability Statement
Acknowledgments
Conflicts of Interest
References
- Ozer, J.; Eisner, N.; Ostrozhenkova, E.; Bacher, A.; Eisenreich, W.; Benharroch, D.; Golan-Goldhirsh, A.; Gopas, J. Nuphar lutea thioalkaloids inhibit the nuclear factor kappaB pathway, potentiate apoptosis and are synergistic with cisplatin and etoposide. Cancer Biol. Ther. 2009, 8, 1860–1868. [Google Scholar] [CrossRef] [PubMed]
- Winer, H.; Ozer, J.; Shemer, Y.; Reichenstein, I.; Eilam-Frenkel, B.; Benharroch, D.; Golan-Goldhirsh, A.; Gopas, J. Nuphar lutea Extracts Exhibit Anti-Viral Activity against the Measles Virus. Molecules 2020, 25, 1657. [Google Scholar] [CrossRef] [PubMed]
- Nepali, K.; Sharma, R.; Sharma, S.; Thakur, A.; Liou, J.-P. Beyond the vaccines: A glance at the small molecule and peptide-based anti-COVID19 arsenal. J. Biomed. Sci. 2022, 29, 65. [Google Scholar] [CrossRef] [PubMed]
- Blaskovich, M.A.T.; Verderosa, A.D. Use of Antiviral Agents and other Therapies for COVID-19. Semin. Respir. Crit. Care Med. 2023, 44, 118–129. [Google Scholar] [CrossRef]
- Lei, S.; Chen, X.; Wu, J.; Duan, X.; Men, K. Small molecules in the treatment of COVID-19. Signal Transduct. Target. Ther. 2022, 7, 387. [Google Scholar] [CrossRef]
- Shoaib, S.; Ansari, M.A.; Kandasamy, G.; Vasudevan, R.; Hani, U.; Chauhan, W.; Alhumaidi, M.S.; Altammar, K.A.; Azmi, S.; Ahmad, W.; et al. An Attention towards the Prophylactic and Therapeutic Options of Phytochemicals for SARS-CoV-2: A Molecular Insight. Molecules 2023, 28, 795. [Google Scholar] [CrossRef]
- Brogna, C.; Costanzo, V.; Brogna, B.; Bisaccia, D.R.; Brogna, G.; Giuliano, M.; Montano, L.; Viduto, V.; Cristoni, S.; Fabrowski, M.; et al. Analysis of Bacteriophage Behavior of a Human RNA Virus, SARS-CoV-2, through the Integrated Approach of Immunofluorescence Microscopy, Proteomics and D-Amino Acid Quantification. Int. J. Mol. Sci. 2023, 24, 3929. [Google Scholar] [CrossRef]
- Food and Drug Administration. Fact Sheet for Healthcare Providers: Emergency Use Authorization for Molnupiravir. 2021. Available online: https://www.fda.gov/news-events/press-announcements/coronavirus-covid-19-update-fda-authorizes-additional-oral-antiviral-treatment-covid-19-certain (accessed on 1 February 2023).
- Food and Drug Administration. Fact Sheet for Healthcare Providers: Emergency Use Authorization for Remdesivir. 2021. Available online: https://www.fda.gov/news-events/press-announcements/fda-approves-first-treatment-covid-19 (accessed on 1 February 2023).
- Food and Drug Administration. Fact Sheet for Healthcare Providers: Emergency Use Authorization for Nirmatrelvir. 2021. Available online: https://www.fda.gov/news-events/press-announcements/coronavirus-covid-19-update-fda-authorizes-first-oral-antiviral-treatment-covid-19 (accessed on 1 February 2023).
- Waidha, K.; Zurgil, U.; Ben-Zeev, E.; Gopas, J.; Rajendran, S.; Golan-Goldhirsh, A. Inhibition of Cysteine Proteases by 6,6′-Dihydroxythiobinupharidine (DTBN) from Nuphar lutea. Molecules 2021, 26, 4743. [Google Scholar] [CrossRef]
- Waidha, K.; Saxena, A.; Kumar, P.; Sharma, S.; Ray, D.; Saha, B. Design and identification of novel annomontine analogues against SARS-CoV-2: An in-silico approach. Heliyon 2021, 7, e06657. [Google Scholar] [CrossRef]
- Yin, W.; Luan, X.; Li, Z.; Zhou, Z.; Wang, Q.; Gao, M.; Wang, X.; Zhou, F.; Shi, J.; You, E.; et al. Structural basis for inhibition of the SARS-CoV-2 RNA polymerase by suramin. Nat. Struct. Mol. Biol. 2021, 28, 319–325. [Google Scholar] [CrossRef]
- Ozer, J.; Levi, T.; Golan-Goldhirsh, A.; Gopas, J. Anti-inflammatory effect of a Nuphar lutea partially purified leaf extract in murine models of septic shock. J. Ethnopharmacol. 2015, 161, 86–91. [Google Scholar] [CrossRef] [PubMed]
- El-On, J.; Ozer, L.; Gopas, J.; Sneir, R.; Golan-Goldhirsh, A. Nuphar lutea: In vitro anti-leishmanial activity against Leishmania major promastigotes and amastigotes. Phytomedicine 2009, 16, 788–792. [Google Scholar] [CrossRef] [PubMed]
- El-On, J.; Ozer, L.; Gopas, J.; Sneir, R.; Enav, H.; Luft, N.; Davidov, G.; Golan-Goldhirsh, A. Antileishmanial activity in Israeli plants. Ann. Trop. Med. Parasitol. 2009, 103, 297–306. [Google Scholar] [CrossRef] [PubMed]
- Ozer, L.; El-On, J.; Golan-Goldhirsh, A.; Gopas, J. Leishmania major: Anti-leishmanial activity of Nuphar lutea extract mediated by the activation of transcription factor NF-κB. Exp. Parasitol. 2010, 126, 510–516. [Google Scholar] [CrossRef]
- Levy, D.H.; Chapple, I.L.C.; Shapira, L.; Golan-Goldhirsh, A.; Gopas, J.; Polak, D. Nupharidine enhances Aggregatibacter actinomycetemcomitans clearance by priming neutrophils and augmenting their effector functions. J. Clin. Periodontol. 2019, 46, 62–71. [Google Scholar] [CrossRef]
- Ozer, J.; Fishman, D.; Eilam, B.; Golan-Goldhirsh, A.; Gopas, J. Anti-Metastatic Effect of Semi-Purified Nuphar Lutea Leaf Extracts. J. Cancer 2017, 8, 1433–1440. [Google Scholar] [CrossRef]
- Muduli, S.; Golan-Goldhirsh, A.; Gopas, J.; Danilenko, M. Cytotoxicity of Thioalkaloid-Enriched Nuphar lutea Extract and Purified 6,6′-Dihydroxythiobinupharidine in Acute Myeloid Leukemia Cells: The Role of Oxidative Stress and Intracellular Calcium. Pharmaceuticals 2022, 15, 410. [Google Scholar] [CrossRef]
- Dalvie, E.D.; Gopas, J.; Golan-Goldhirsh, A.; Osheroff, N. 6,6′-Dihydroxythiobinupharidine as a poison of human type II topoisomerases. Bioorg. Med. Chem. Lett. 2019, 29, 1881–1885. [Google Scholar] [CrossRef]
- Waidha, K.; Anto, N.P.; Jayaram, D.R.; Golan-Goldhirsh, A.; Rajendran, S.; Livneh, E.; Gopas, J. 6,6′-Dihydroxythiobinupharidine (DTBN) Purified from Nuphar lutea Leaves Is an Inhibitor of Protein Kinase C Catalytic Activity. Molecules 2021, 26, 2785. [Google Scholar] [CrossRef]
- Farahani, M.; Niknam, Z.; Mohammadi Amirabad, L.; Amiri-Dashatan, N.; Koushki, M.; Nemati, M.; Danesh Pouya, F.; Rezaei-Tavirani, M.; Rasmi, Y.; Tayebi, L. Molecular pathways involved in COVID-19 and potential pathway-based therapeutic targets. Biomed. Pharmacother. 2022, 145, 112420. [Google Scholar] [CrossRef]
- Robles, J.P.; Zamora, M.; Adan-Castro, E.; Siqueiros-Marquez, L.; Martinez de la Escalera, G.; Clapp, C. The spike protein of SARS-CoV-2 induces endothelial inflammation through integrin α5β1 and NF-κB signaling. J. Biol. Chem. 2022, 298, 101695. [Google Scholar] [CrossRef] [PubMed]
- Neufeldt, C.J.; Cerikan, B.; Cortese, M.; Frankish, J.; Lee, J.-Y.; Plociennikowska, A.; Heigwer, F.; Prasad, V.; Joecks, S.; Burkart, S.S.; et al. SARS-CoV-2 infection induces a pro-inflammatory cytokine response through cGAS-STING and NF-κB. Commun. Biol. 2022, 5, 45. [Google Scholar] [CrossRef] [PubMed]
- Ji, H.-L.; Song, W.; Gao, Z.; Su, X.-F.; Nie, H.-G.; Jiang, Y.; Peng, J.-B.; He, Y.-X.; Liao, Y.; Zhou, Y.-J.; et al. SARS-CoV proteins decrease levels and activity of human ENaC via activation of distinct PKC isoforms. Am. J. Physiol. Lung Cell. Mol. Physiol. 2009, 296, L372–L383. [Google Scholar] [CrossRef] [PubMed]
- Huang, C.; Feng, F.; Shi, Y.; Li, W.; Wang, Z.; Zhu, Y.; Yuan, S.; Hu, D.; Dai, J.; Jiang, Q.; et al. Protein Kinase C Inhibitors Reduce SARS-CoV-2 Replication in Cultured Cells. Microbiol. Spectr. 2022, 10, e0105622. [Google Scholar] [CrossRef] [PubMed]
- Zhao, M.-M.; Yang, W.-L.; Yang, F.-Y.; Zhang, L.; Huang, W.-J.; Hou, W.; Fan, C.-F.; Jin, R.-H.; Feng, Y.-M.; Wang, Y.-C.; et al. Cathepsin L plays a key role in SARS-CoV-2 infection in humans and humanized mice and is a promising target for new drug development. Signal Transduct. Target. Ther. 2021, 6, 134. [Google Scholar] [CrossRef]
- Gomes, C.P.; Fernandes, D.E.; Casimiro, F.; da Mata, G.F.; Passos, M.T.; Varela, P.; Mastroianni-Kirsztajn, G.; Pesquero, J.B. Cathepsin L in COVID-19: From Pharmacological Evidences to Genetics. Front. Cell. Infect. Microbiol. 2020, 10, 589505. [Google Scholar] [CrossRef]
- Huang, I.-C.; Bosch, B.J.; Li, F.; Li, W.; Lee, K.H.; Ghiran, S.; Vasilieva, N.; Dermody, T.S.; Harrison, S.C.; Dormitzer, P.R.; et al. SARS coronavirus, but not human coronavirus NL63, utilizes cathepsin L to infect ACE2-expressing cells. J. Biol. Chem. 2006, 281, 3198–3203. [Google Scholar] [CrossRef]
- Bosch, B.J.; Bartelink, W.; Rottier, P.J.M. Cathepsin L functionally cleaves the severe acute respiratory syndrome coronavirus class I fusion protein upstream of rather than adjacent to the fusion peptide. J. Virol. 2008, 82, 8887–8890. [Google Scholar] [CrossRef]
- Zhou, P.; Yang, X.-L.; Wang, X.-G.; Hu, B.; Zhang, L.; Zhang, W.; Si, H.-R.; Zhu, Y.; Li, B.; Huang, C.-L.; et al. A pneumonia outbreak associated with a new coronavirus of probable bat origin. Nature 2020, 579, 270–273. [Google Scholar] [CrossRef]
- Hashimoto, R.; Sakamoto, A.; Deguchi, S.; Yi, R.; Sano, E.; Hotta, A.; Takahashi, K.; Yamanaka, S.; Takayama, K. Dual inhibition of TMPRSS2 and Cathepsin Bprevents SARS-CoV-2 infection in iPS cells. Mol. Ther. Nucleic Acids 2021, 26, 1107–1114. [Google Scholar] [CrossRef]
- Ho, J.S.Y.; Mok, B.W.-Y.; Campisi, L.; Jordan, T.; Yildiz, S.; Parameswaran, S.; Wayman, J.A.; Gaudreault, N.N.; Meekins, D.A.; Indran, S.V.; et al. TOP1 inhibition therapy protects against SARS-CoV-2-induced lethal inflammation. Cell 2021, 184, 2618–2632.e17. [Google Scholar] [CrossRef] [PubMed]
- Zhang, Q.; Radvak, P.; Lee, J.; Xu, Y.; Cao-Dao, V.; Xu, M.; Zheng, W.; Chen, C.Z.; Xie, H.; Ye, Y. Mitoxantrone modulates a heparan sulfate-spike complex to inhibit SARS-CoV-2 infection. Sci. Rep. 2022, 12, 6294. [Google Scholar] [CrossRef] [PubMed]
- Armed Forces Institute of Pathology (U.S.). Laboratory Methods in Histotechnology; American Registry of Pathology: Silver Spring, MD, USA, 1992. [Google Scholar]
- Berg, S.; Kutra, D.; Kroeger, T.; Straehle, C.N.; Kausler, B.X.; Haubold, C.; Schiegg, M.; Ales, J.; Beier, T.; Rudy, M.; et al. ilastik: Interactive machine learning for (bio)image analysis. Nat. Methods 2019, 16, 1226–1232. [Google Scholar] [CrossRef] [PubMed]
- Schindelin, J.; Arganda-Carreras, I.; Frise, E.; Kaynig, V.; Longair, M.; Pietzsch, T.; Preibisch, S.; Rueden, C.; Saalfeld, S.; Schmid, B.; et al. Fiji: An open-source platform for biological-image analysis. Nat. Methods 2012, 9, 676–682. [Google Scholar] [CrossRef]

| Motif | Range |
|---|---|
| Motif G | 499–511 |
| Motif F | 544–560 |
| Motif A | 612–626 |
| Motif B | 678–710 |
| Motif C | 753–767 |
| Motif D | 771–796 |
| Motif E | 810–820 |
| S.No. | Compound | RdRp ΔG (Kcal/mol) | ACE2 ΔG (Kcal/mol) |
|---|---|---|---|
| 1. | DTBN | −38.26 | −27.88 |
| 2. | Control | Suramin (−59.15) | MLN-4760 (−73.89) |
Disclaimer/Publisher’s Note: The statements, opinions and data contained in all publications are solely those of the individual author(s) and contributor(s) and not of MDPI and/or the editor(s). MDPI and/or the editor(s) disclaim responsibility for any injury to people or property resulting from any ideas, methods, instructions or products referred to in the content. |
© 2023 by the authors. Licensee MDPI, Basel, Switzerland. This article is an open access article distributed under the terms and conditions of the Creative Commons Attribution (CC BY) license (https://creativecommons.org/licenses/by/4.0/).
Share and Cite
Weiss, S.; Waidha, K.; Rajendran, S.; Benharroch, D.; Khalilia, J.; Levy, H.; Bar-David, E.; Golan-Goldhirsh, A.; Gopas, J.; Ben-Shmuel, A. In Vitro and In Vivo Therapeutic Potential of 6,6′-Dihydroxythiobinupharidine (DTBN) from Nuphar lutea on Cells and K18-hACE2 Mice Infected with SARS-CoV-2. Int. J. Mol. Sci. 2023, 24, 8327. https://doi.org/10.3390/ijms24098327
Weiss S, Waidha K, Rajendran S, Benharroch D, Khalilia J, Levy H, Bar-David E, Golan-Goldhirsh A, Gopas J, Ben-Shmuel A. In Vitro and In Vivo Therapeutic Potential of 6,6′-Dihydroxythiobinupharidine (DTBN) from Nuphar lutea on Cells and K18-hACE2 Mice Infected with SARS-CoV-2. International Journal of Molecular Sciences. 2023; 24(9):8327. https://doi.org/10.3390/ijms24098327
Chicago/Turabian StyleWeiss, Shay, Kamran Waidha, Saravanakumar Rajendran, Daniel Benharroch, Jannat Khalilia, Haim Levy, Elad Bar-David, Avi Golan-Goldhirsh, Jacob Gopas, and Amir Ben-Shmuel. 2023. "In Vitro and In Vivo Therapeutic Potential of 6,6′-Dihydroxythiobinupharidine (DTBN) from Nuphar lutea on Cells and K18-hACE2 Mice Infected with SARS-CoV-2" International Journal of Molecular Sciences 24, no. 9: 8327. https://doi.org/10.3390/ijms24098327
APA StyleWeiss, S., Waidha, K., Rajendran, S., Benharroch, D., Khalilia, J., Levy, H., Bar-David, E., Golan-Goldhirsh, A., Gopas, J., & Ben-Shmuel, A. (2023). In Vitro and In Vivo Therapeutic Potential of 6,6′-Dihydroxythiobinupharidine (DTBN) from Nuphar lutea on Cells and K18-hACE2 Mice Infected with SARS-CoV-2. International Journal of Molecular Sciences, 24(9), 8327. https://doi.org/10.3390/ijms24098327

